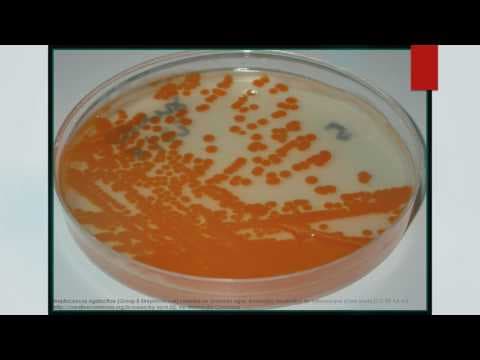
RCOG savjetuje BHSB profilaksu kod prijevremenog poroda

Čini se da su majke izvor većine kasnih neonatalnih infekcija streptokokima grupe B (BHSB), pokazuju rezultati prospektivnog kohortnog istraživanja koje je objavio Alberto Berardi s kolegama iz Azienda-Universitaria Proclinico iz Modene u Italiji u časopisu Pediatrics.
Prijevremeno rođena djeca imaju višu stopu pojavnosti kasne neonatalne BHSB infekcije (1.4/1000 rođenih), a one uzrokuju i veću smrtnost. Antibiotici koji se primijene u porođaju povezani su s blažim tijekom kasne BHSB infekcije i odgođenim nastupom simptoma.
U periodu između 2003. i 2010. godine Berardi i kolege ispitivali su pojavu kasne BHSB infekcije u novorođenčadi.
Kasna BHSB infekcija (beta-hemolitički streptokok grupe B) iskazuje se sepsom, meningitisom i/ili žarišnim infekcijama. Utvrđeno je da je rizik meningitisa i smrti veći što infekcija BHSB-om nastupi ranije.
U oko 50% prijevremeno rođene djece kasna infekcija BHSB-om dijagnosticirana se već u bolnici. Ta su djeca imala manju porođajnu težinu, bila mlađe gestacijske dobi i imala puno teži tijek bolesti.
Učestalost kasne infekcije BHSB-om u terminski rođene djece bila je 0.24/1000 živorođenih.
U vrijeme kada je novorođenčadi dijagnosticiran BHSB većina majki (64%) imala je BHSB, a neke od njih (6%) imale su mastitis (upalu dojki).
Ranije su objavljena izvješća po kojima majčino mlijeko zaraženo BHSB-om, čak i ako nije bilo klinički vidljivog mastitisa, može biti uzrok kasne pojave BHSB infekcije. Autori ovog istraživanja također su potvrdili da je izvor infekcije bilo majčino mlijeko, ističući da u nekim slučajevima nije bilo pojave mastitisa u majke. Naglašava se također da se mlijeko majki bez mastitisa rutinski ne ispituje na prisutnost bakterija.
Trećina majki koje su imale probir prije porođaja i u doba kasne pojave infekcije BHSB-om imale su negativne kulture. Više od polovine žena koje su na probiru bile BHSB pozitivne, primile su antibiotike, dio njih ipak je prenio bakteriju na dijete, no te su infekcije imale blaži tijek.
Pediatrics, published on-line January 7, 2013.